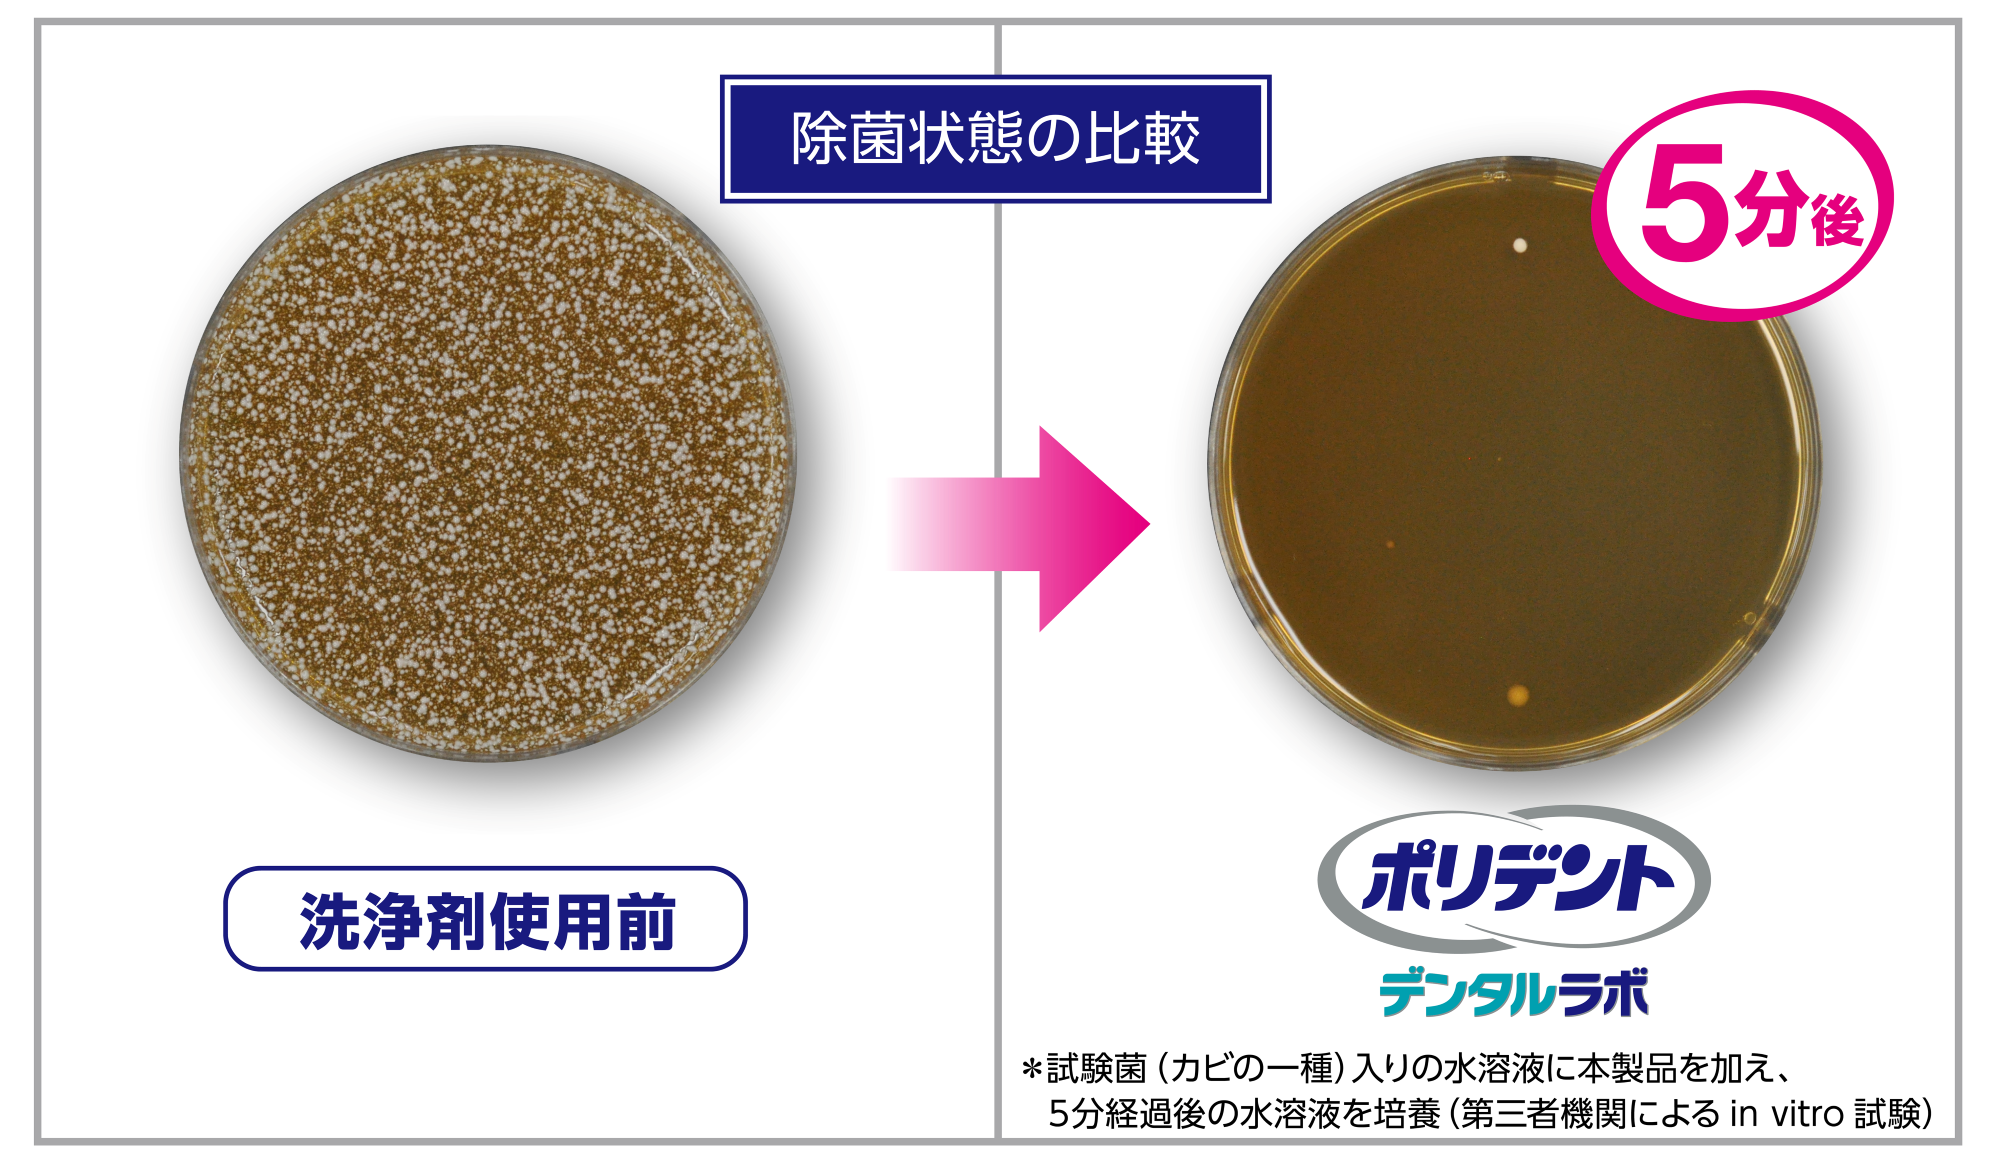

グラクソ・スミスクライン・コンシューマー・ヘルスケア・ジャパン株式会社のプレスリリース
グラクソ・スミスクライン・コンシューマー・ヘルスケア・ジャパン株式会社(代表取締役社長:野上 麻理、本社:東京都港区、以下、GSKコンシューマー・ヘルスケア)は、「ポリデントデンタルラボ マウスピース(ガード)・矯正用リテーナー用洗浄剤」が、利便性と効果、また歯科保健・歯科医療の発展及び普及に寄与することが評価され、マウスピース洗浄剤としては初の公益社団法人日本歯科医師会の推薦を受けましたことをお知らせします。

歯科矯正だけでなく、スポーツ界でもマウスピース着用者が増加
近年、世界的な審美歯科の発展やオンライン診療で始められるセルフ歯列矯正サービスの増加に伴い、リテーナー(矯正治療後の保定装置)やアライナー(マウスピース型の矯正装置)の普及が進んでいます。さらに、スポーツにおける歯科の重要性が高まり、ラグビーやボクシングだけでなく、サッカー、野球、スポーツジムでのトレーニングなどの身近なスポーツでもマウスピースを着用する人も増加。日本では、現在約1,400万人がこれらの取り外し可能な口腔内装具を使用していると推計*3されます。
口腔内衛生を保つためには、マウスピース専用洗浄剤での洗浄と除菌が不可欠!
マウスピースの洗浄方法として、水洗いだけ、歯磨剤と歯ブラシで磨くなど、独自の方法で洗浄している方が圧倒的に多い状況にあります。これらの方法はマウスピースを傷つけるだけでなく、洗浄不足による口腔内衛生状態の悪化が懸念されます。歯列矯正中、1日約20時間はマウスピースを装着するため、装具を常に清潔な状態に保つ必要があります。睡眠時は唾液の分泌が減少して自浄作用が低下するため、口腔内の菌は約8倍*3にも増えます。お手入れを怠ると、細菌が繁殖して着色や悪臭の原因となるだけではなくカビが発生することもあります。この状態が続くと虫歯や歯周病の悪化にもつながるため、専用の洗浄剤でしっかりと汚れを除去し、除菌することが重要です。
ポリデント デンタルラボ 3つの特長
「ポリデントデンタルラボ マウスピース(ガード)・矯正用リテーナー用洗浄剤」は 、5分間浸すだけで、カビの一種やニオイの原因菌を 99.9%*2除菌。マウスピース等の頑固なヨゴレ、ニオイを取り、清潔に保ちます。研磨剤を配合していないため、 マウスピース等を傷つけずに洗浄できます。
■特長① 1回たったの5分で徹底洗浄。ニオイの原因菌・黄ばみを除去します。
■特長② ウイルス*4、ニオイの原因となる細菌を99.9%*2除去します。
■特長③ 歯科医推奨No.1*5、マウスピース洗浄剤では初*!公益社団法人日本歯科医師会推薦*1
*…出典 歯科衛生製品の推薦について|日本歯科医師会 (jda.or.jp)
*1…対象:ポリデントデンタルラボマウスピース洗浄剤。日本歯科医師会の推薦は、本製品の品質・性能等を保証するものではありません。また、製造・販売等に関与するものではありません
*2… GSK調べ (in vitro)
*3…GSK調べ
*4…すべての菌・ウイルスを除去するわけではありません
*5…歯科医師サンプル(200名)に対するオンライン定量調査に基づく(2022年6月8日~18日実施)/第三者調査機関を使用してのGSK調べ



